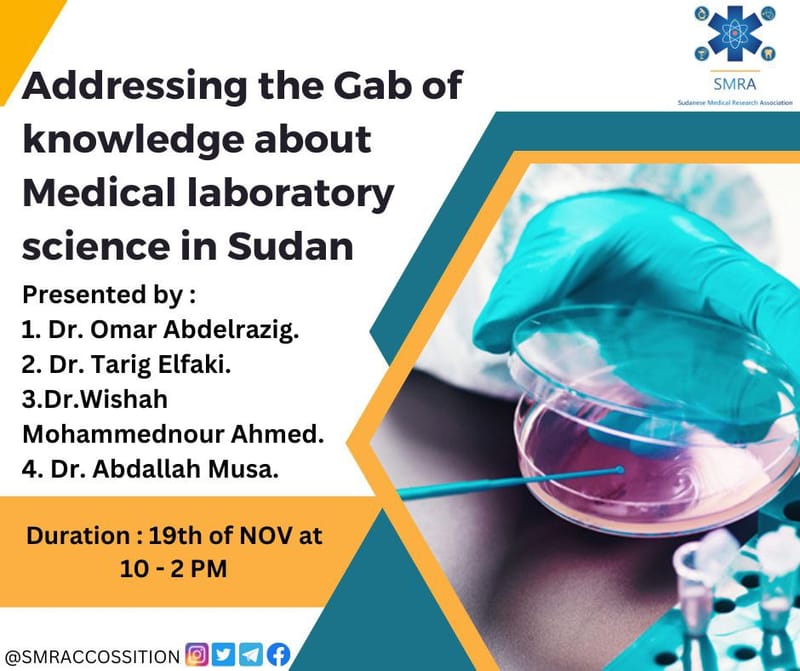
Workshop announcement

SMRA News #Sudanese Medical Research Association
الاسبوع العالمي للصحة النفسية للطفل
✨ بالنيابة عن كل طفل يستحق أن يعيش بسعادة وهدوء ✨ بمناسبة الأسبوع العالمي للصحة النفسية للطفل، نحتفي معاً بهذه المناسبة المهمة التي تذكرنا بأن السلامة النفسية لأطفالنا هي أساس بناء مستقبلهم.
Wasla Research Program
From Concept to Publication: Join the "Wasla" Research Program! Got a research idea but no supervisor? Have the passion but no team? SMRA is proud to introduce "Wasla Research Program"—a dedicated incubator designed to connect ambitious researchers with world-class mentors.
⭕️ Application for SMRA Membership
Join the Sudanese Medical Research Association (SMRA) 🌟 Are you passionate about medical research? Here’s your chance to connect, learn, and grow with like-minded individuals.
Advisory Council for the 2025-2026 Executive Term
Elections Committee for the 2025 - 2026 Executive Term The Advisory Council for the 2025 - 2026 Executive Term Constitutional Duties of the Advisory Council: - It consists of five members from previous executive terms of the Association who have contributed to its success and possess a thorough understanding of the Association's regulations.
⭕ إعلان هام لجميع المتقدمين للعضوية.
English below 👇 ⭕ إعلان هام لجميع المتقدمين للعضوية. [الجمعية السودانية للبحث الطبي - سمرا] تتقدم الجمعية السودانية للبحث الطبي بخالص الشكر والتقدير لجميع السادة المتقدمين للحصول على عضوية الجمعية. تهدف الجمعية السودانية للبحث الطبي إلى تعزيز ودعم البحث العلمي في المجال الطبي بالسودان، وتوفير منصة للباحثين للتواصل وتبادل المعرفة.
التعريف بأجهزة الجمعية واختصاصاتها
English below 👇 الجمعية السودانية للبحث الطبي - سمرا التعريف بأجهزة الجمعية واختصاصاتها: 1. الجمعية العمومية: يتكون من جميع الأعضاء المسجلين الحاصلين على العضوية الكاملة في الجمعية. اختصاصاتها: أ. انتخاب المجلس الاستشاري ب. اجازة خطاب الدورة والميزانية. ج. تعديل دستور الجمعية من ثم إجازته.
SMRA events summary 2018
Below is the summary of the events done in 2018. #SMRA_events #SMRA_news